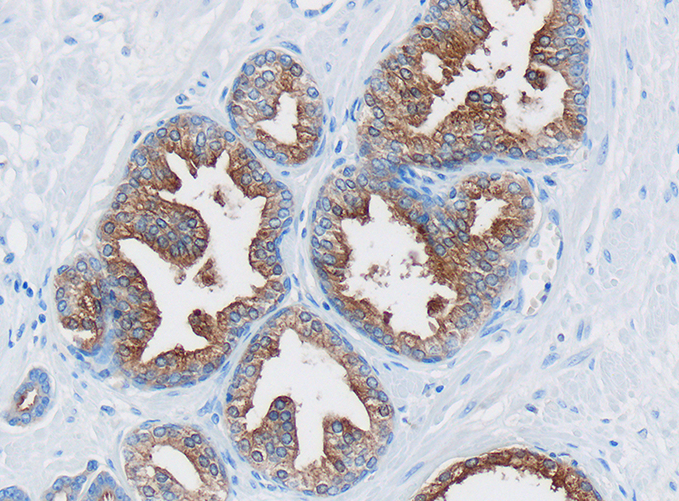

Da «click» sobre las imágenes para agrandarlas y consultar sus leyendas.
TESTÍCULO
El sistema genital masculino se compone de los testículos, las vías espermáticas, las glándulas accesorias y el pene.
La función del testículo es producir hormonas sexuales masculinas y espermatozoides.






CONDUCTO DEL EPIDÍDIMO
Revestido de un epitelio cilíndrico pseudoestratificado con estereocilios.






VESÍCULA SEMINAL
Las glándulas accesorias son las vesículas seminales, la próstata y las glándulas bulbouretrales, productoras
de secreciones esenciales para la función reproductora del hombre.






PRÓSTATA
La próstata es un conjunto de entre 30 y 50 glándulas tubuloalveolares ramificadas y envuelven una porción de la uretra denominada uretra prostática
Fosfatasa ácida: Enzima involucrada en la licuefacción del semen. Antígeno prostático específico (PSA): Facilita la licuefacción del semen.Iones de zinc: Mejoran la estabilidad del ADN espermático. Citrato: Actúa como buffer, regulando el pH. Espermina y espermidina: Estabilizan el ADN de los espermatozoides. Enzimas proteolíticas: Ayudan a disolver el coágulo seminal. Ácido cítrico: Contribuye al mantenimiento del pH del semen.

PENE

